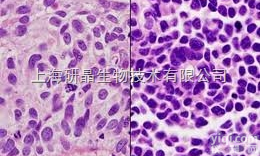
<em></em>C<em></em>a<em></em>l<em></em>u<em></em>-<em></em>6<em></em>�<em></em>�<em></em>�<em></em>�<em></em>�<em></em>�<em></em>,<em>人肺癌细胞</em><em></em>�<em></em>�<em></em>�<em></em>�<em></em>�<em></em>�<em></em>�<em></em>�<em></em>�<em></em>�<em></em>�<em></em>�<em></em>�<em></em>�<em></em>�<em></em>�<em></em>�<em></em>�<em></em>
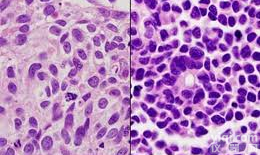
<em></em>C<em></em>a<em></em>l<em></em>u<em></em>-<em></em>6<em></em>�<em></em>�<em></em>�<em></em>�<em></em>�<em></em>�<em></em>�<em></em>�<em></em>�<em>人肺癌细胞</em><em></em>

Calu-1з»Ҷиғһ|дәәиӮәзҷҢз»Ҷиғһ|Calu-1з»Ҷиғһ|дәәиӮәзҷҢз»Ҷиғһ|
- е“ҒзүҢпјҡATCC/дёӯ科йҷў/еҗҢжөҺеӨ§еӯҰ
- еһӢеҸ·пјҡ69
- дә§ең°пјҡе’ЁиҜўе®ўжңҚ
- дҫӣеә”е•ҶпјҡдёҠжө·дј з§Ӣз”ҹзү©з§‘жҠҖжңүйҷҗе…¬еҸё
- дҫӣеә”е•ҶжҠҘд»·пјҡпҝҘ800 - 2800
- ж ҮзӯҫпјҡCalu-1з»Ҷиғһ|дәәиӮәзҷҢз»Ҷиғһ|Calu-1з»Ҷиғһ|дәәиӮәзҷҢз»Ҷиғһ|гҖҒCalu-1з»Ҷиғһ|дәәиӮәзҷҢз»Ҷиғһ|Calu-1з»Ҷиғһ|дәәиӮәзҷҢз»Ҷиғһ|д»·ж јгҖҒCalu-1з»Ҷиғһ|дәәиӮәзҷҢз»Ҷиғһ|Calu-1з»Ҷиғһ|дәәиӮәзҷҢз»Ҷиғһ|еҺӮ家гҖҒCalu-1гҖҒгҖҒдёҠжө·дј з§Ӣз”ҹзү©з§‘жҠҖжңүйҷҗе…¬еҸё
дҝЎжҒҜеЈ°жҳҺпјҡжң¬дә§е“Ғдҫӣеә”дҝЎжҒҜз”ұд»ӘеҷЁзҪ‘дёәжӮЁж•ҙеҗҲпјҢдҫӣеә”е•ҶдёәпјҲдёҠжө·дј з§Ӣз”ҹзү©з§‘жҠҖжңүйҷҗе…¬еҸёпјүпјҢеҶ…е®№еҢ…жӢ¬
пјҲCalu-1з»Ҷиғһ|дәәиӮәзҷҢз»Ҷиғһ|Calu-1з»Ҷиғһ|дәәиӮәзҷҢз»Ҷиғһ|пјүзҡ„е“ҒзүҢгҖҒеһӢеҸ·гҖҒжҠҖжңҜеҸӮж•°гҖҒиҜҰз»Ҷд»Ӣз»ҚзӯүпјӣеҰӮжһңжӮЁжғідәҶи§ЈжӣҙеӨҡе…ідәҺ
пјҲCalu-1з»Ҷиғһ|дәәиӮәзҷҢз»Ҷиғһ|Calu-1з»Ҷиғһ|дәәиӮәзҷҢз»Ҷиғһ|пјүзҡ„дҝЎжҒҜпјҢиҜ·зӣҙжҺҘиҒ”зі»дҫӣеә”е•ҶпјҢз»ҷдҫӣеә”е•Ҷз•ҷиЁҖпјҒ